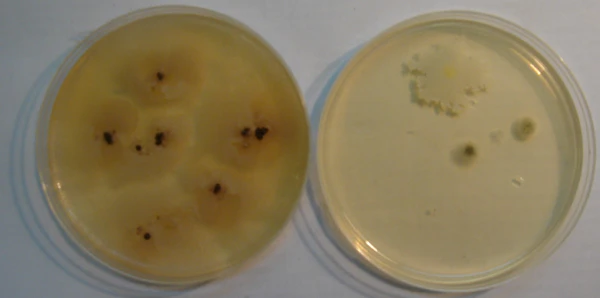

Микробиологический анализ почв
Микробиологический анализ почв — анализ почв, проводимый с целью определения наличия в почве бактерий, их видов и численности.
Подготовка проб почвы с исследуемых участков
Пробы почвы нужно брать с помощью кернов диаметром около 10 мм на глубину 10—20 см. Керны лучше предварительно простерилизовать в кипящей воде (100 °C).
Пробы следует помещать в стерильные чашки Петри, которые затем нужно загерметизировать. ½ весовую часть каждой пробы обычно берут на химический анализ (изучение концентрации азотосодержащих ионов), остальная часть идёт на микробиологический анализ.
Изучение экзоферментной активности микроорганизмов на исследуемых участках
Микробиологическая активность почв может быть определена по протеазной активности почвенноживущих микроорганизмов, а протеазная активность почв определяется активностью экзоферментов почвенных микроорганизмов и зависит от их численности и активности. Экзоферменты- ферменты, выделяемые микроорганизмами во внешнюю среду, которые расщепляют белки, полисахариды и липиды.
В чашки Петри с образцами почвы нужно поместить нарезанную по 2-3 кадра засвеченную фотоплёнку, предварительно замоченную в воде на 10 минут. Воду следует предварительно простерилизовать кипячением в течение 10 минут (100 °C). Также лучше поместить один фрагмент плёнки в пустую стерильную чашку Петри (контроль) для того, чтобы в конце эксперимента сравнить полученные результаты с контролем и минимизировать риск возникновения погрешностей.
Далее образцы почвы нужно выдерживать при комнатной температуре (20 °C) 9 дней. Затем плёнку следует осторожно вынуть и промыть под струёй воды, после чего высушить. После этого нужно подсчитать процент «съеденного» эмульсионного слоя по палетке. Чем выше процент разрушения эмульсионного слоя, тем выше экзоферментная активность почвы.
Окраска по методу Грама
Особенностью окраски по методу Грама является неодинаковое отношение различных микробов к красителям трифенилметановой группы: генцианвиолету, метилвиолету, кристалвиолету. Микробы, входящие в группу грамположительных дают прочное соединение с указанными красителями и йодом. Окрашенные микробы не обесцвечиваются при воздействии на них спиртом, вследствие чего при дополнительной окраске фуксином грамположительные микробы не изменяют первоначально принятый фиолетовый цвет. Грамотрицательные микроорганизмы образуют с генциан-, кристалл- или метилвиолетом и йодом легко разрушающееся под действием спирта соединение, в результате чего они обесцвечиваются и затем окрашиваются фуксином, приобретая красный цвет. Отношение микроорганизмов к окрашиванию по Грамму имеет большое диагностическое значение.
Небольшое количество почвенной пробы следует высеять в чашки Петри с водорослевым агаром с помощью микробиологической петли, далее засеянные чашки Петри нужно выдержать при комнатной температуре в течение 9 дней. Также лучше сделать контрольный посев из воздуха, чтобы позже сравнить колонии микрооганизмов, выросших в разных чашках Петри, и знать какие микроорганизмы могли попасть из воздуха, а не из почвы.
На чистое, обезжиренное предметное стекло поместить каплю дистиллированной воды, затем с помощью микробиологической петли в неё внести небольшое количество выросшей на агаре микробной культуры. Далее нужно сделать мазки и фиксировать их на пламени. Лучше сделать по 2-3 мазка на каждый образец почвы и один контрольный мазок.
Окраску микроорганизмов по Граму следует производить следующим образом:
- Мазок, фиксированный на огне, нужно окрашивать через фильтровальную бумагу основным красителем- раствором основного карболового кристалвиолета. Прокрашивание должно длиться 1-2 минуты.
- Далее бумагу следует снять, избыток краски слить и налить раствор Люголя на 1-2 минуты до почернения препарата.
- Далее раствор Люголя нужно опять слить, предметное стекло для обесцвечивания мазка погрузить несколько раз в стаканчик со спиртом; процесс обесцвечивания считается завершённым, когда от мазка перестают отделяться окрашенные в фиолетовый цвет струйки жидкости.
- Затем препарат следует тщательно промыть водопроводной водой и докрасить спиртово-водным раствором фуксина в течение двух минут.
- В конце мазок нужно промыть водой и высушить.
Результат окраски: грамположительные бактерии окрашиваются основной краской в темно- фиолетовый цвет, грамотрицательные бактерии, воспринимая дополнительную окраску, приобретают ярко-малиновый цвет.
См. также
Литература
- Гиляров М. С. Биологический энциклопедический словарь. — М.: Советская энциклопедия, 1983. — 831 с.
- Хоулт Дж. Краткий определитель бактерий Берги. — М.: Мир, 1980. — 496 с.
- Шлегель Г. Общая микробиология. — М.: Мир, 1987. — 567 с.
- Лабинская А. С. Микробиология с техникой микробиологических исследований. — М.: Медицина, 1972. — 480 с.